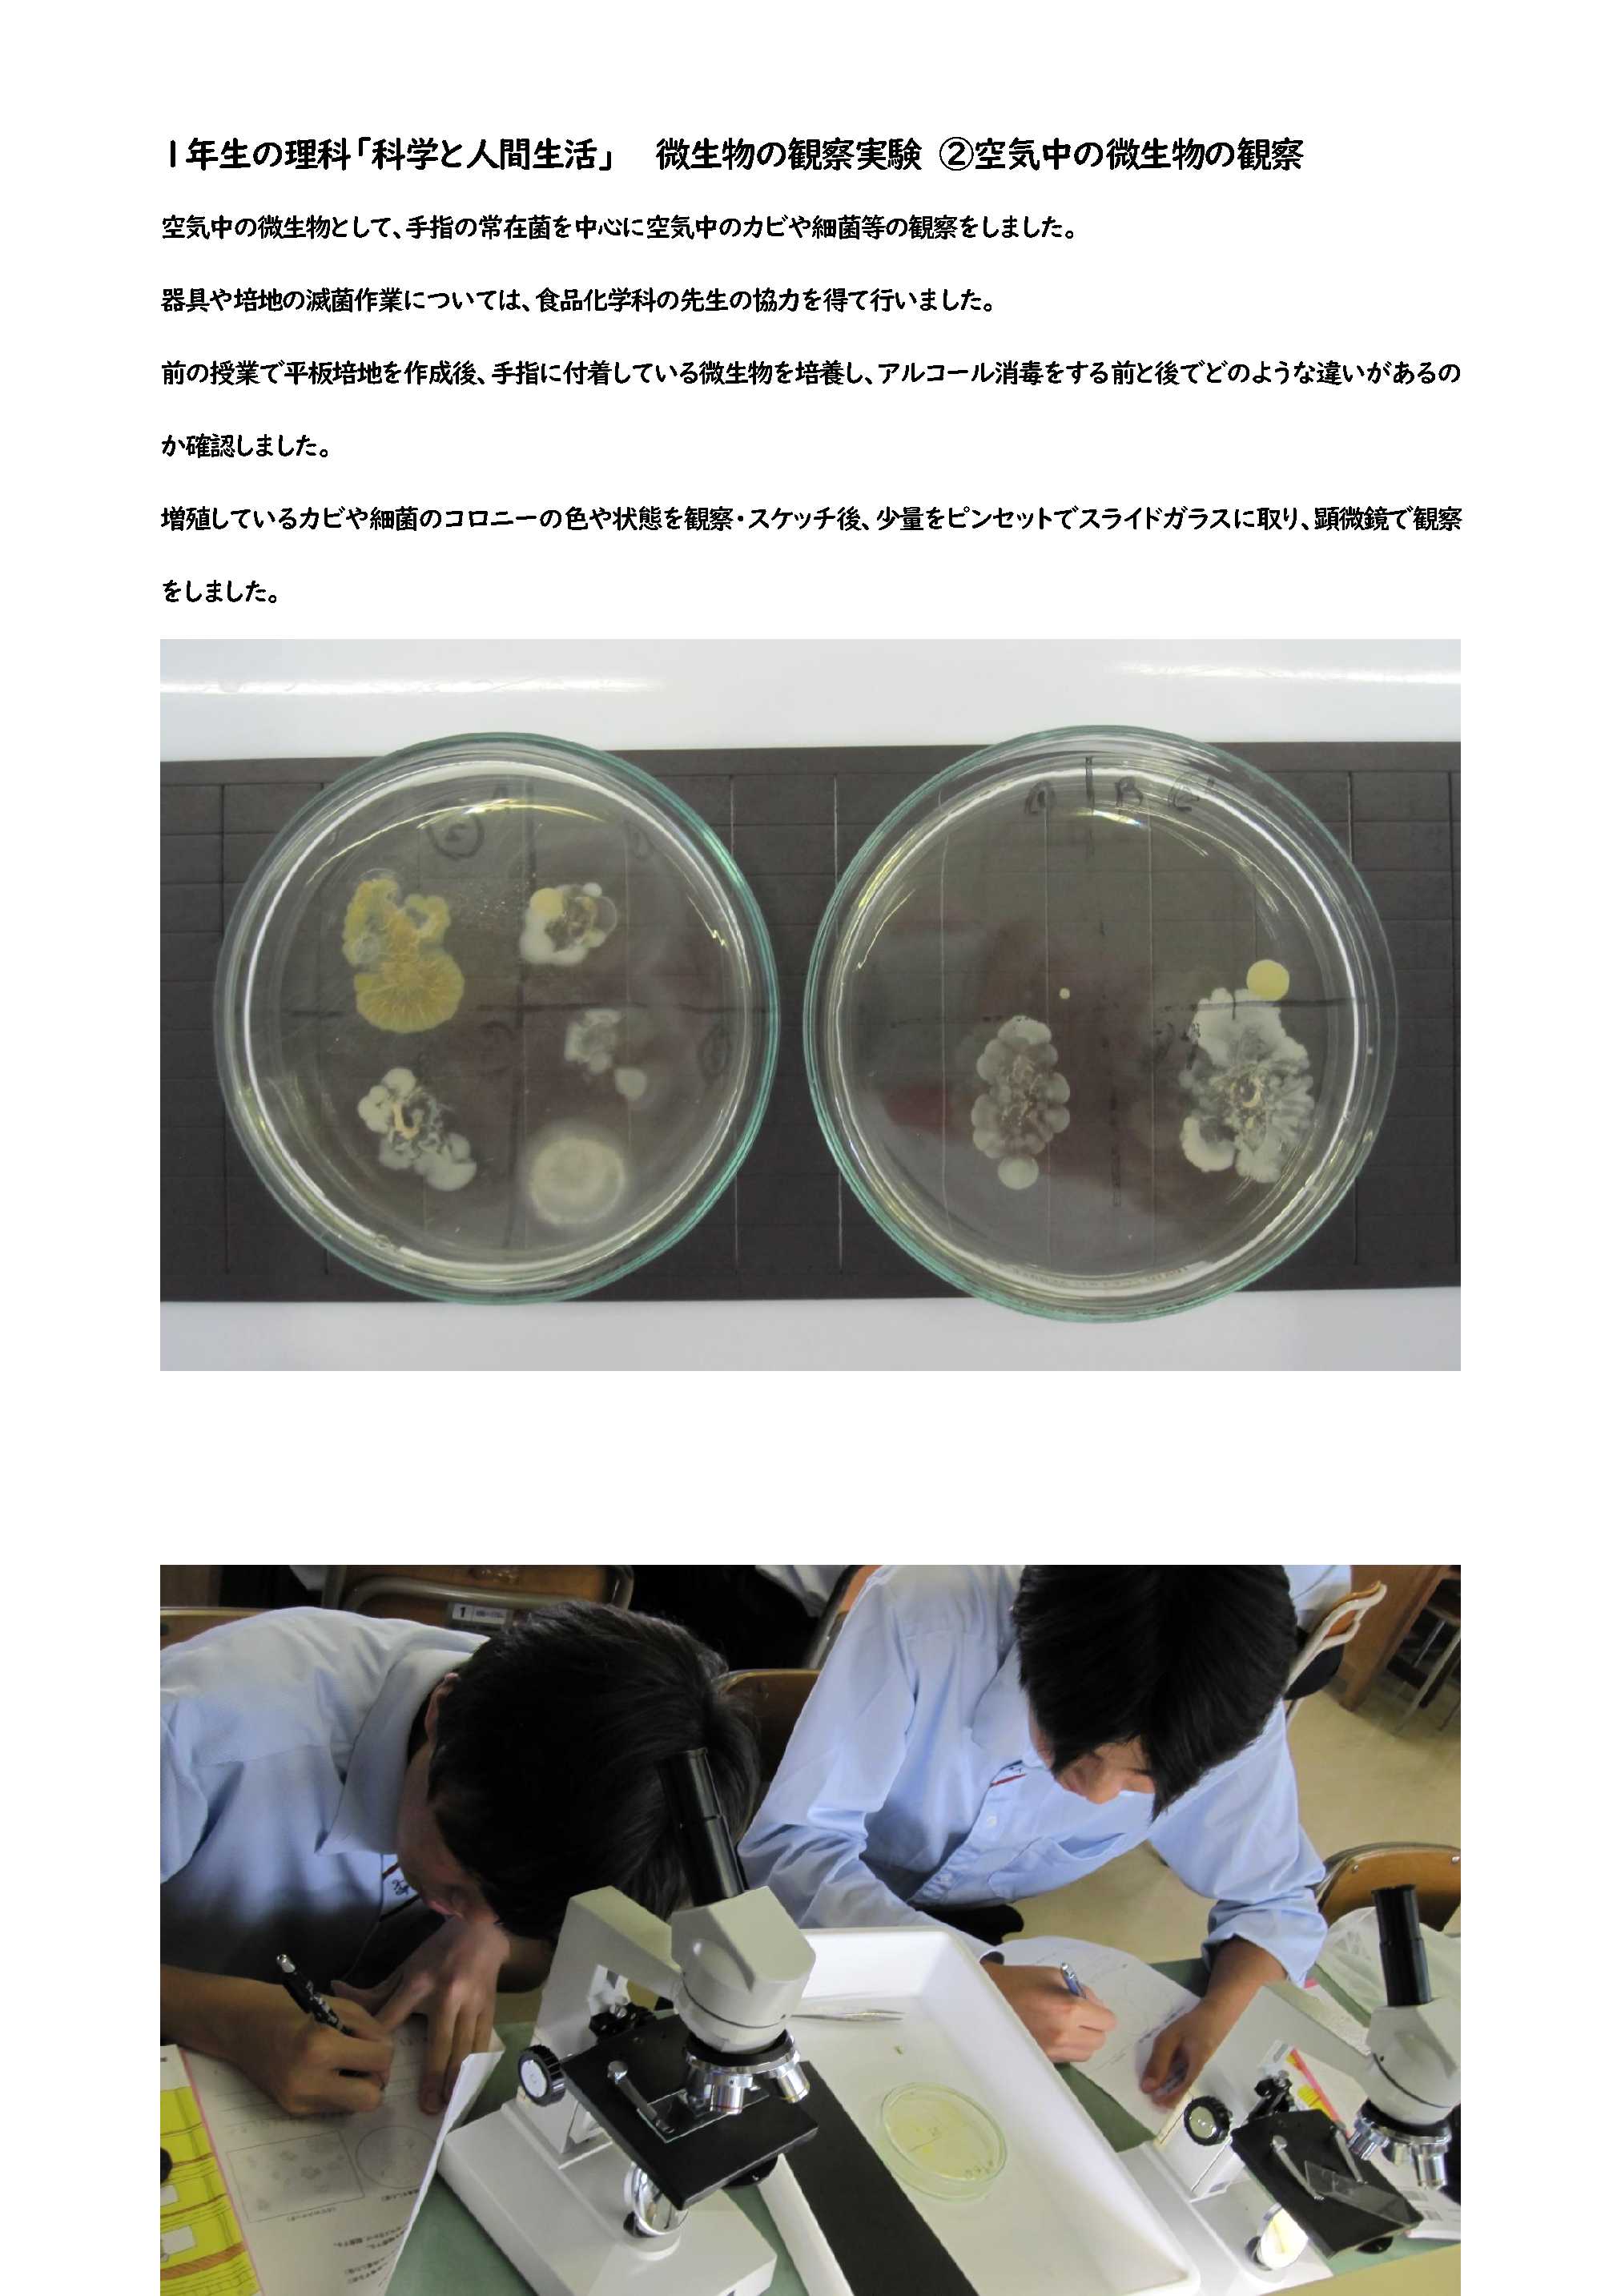

2023年7月の記事一覧
校内自然観察会
菊池農業高校には広い前庭や農場があります。そのため、樹木、昆虫、野鳥、植物、野生動物など多くの生き物を観察することができます。昨年と同様、今年も観察会を実施しました。「この葉のギザギザを鋸歯というんだよ」「これは複数の葉にみえるけど1枚の葉で複葉といいます」などの解説や「これは何という植物でしょうか」クイズ形式で復習しながら学習しました。理科の先生と農業の先生が観察会を案内します。生徒は記録を取りながら、観察しました。生き物の観察では多くの種類を見ることができ楽しいですよこの1時間だけでも、樹木:約30種、植物:約20種、昆虫野鳥爬虫類など:8種見ることができました
皆さんもぜひ自然や生き物に目を向けてみてくださいね
R5 体験入学
本日、7月24月(月)に体験入学を各学科に分かれて実施しました。
内容は次の通りです。
農業科:学科紹介、ドローン飛行見学、野菜など収穫体験、糖度測定、生産物の試食
園芸科:学科紹介、自家製果物を使ったシャーベット試食、ハーバリウム作り、農場見学
畜産科学科:学科紹介、農場見学、乗馬体験、伴侶動物とのふれあい、学校生乳を使ったアイスクリーム試食
食品化学科:学科紹介、製パン実習体験・試食
生活文化科:学科紹介、農場見学、調理実習(フルーツいっぱいゼリー)花とのふれ合い(屋内用ミニ鉢づくり)
中学生及び関係の皆様、猛暑の中での参加本当にありがとうございました。
救急救命法講習会(職員研修)実施
菊池広域連合消防本部西消防署より消防隊員3名来校いただきまして、『救急救命法講習会(職員研修)』を実施しました。内容としては、心肺蘇生法とAEDの使用方法について学びました。また、熱中症・アナフラキシーの対方方法についても教えていただきました。夏休みにも入り、暑い日がこれから続きます。この研修会が役立つ前に、熱中症対策などしっかり行って、事故防止を心がけていきましょう。




1学期終業式
令和5年度1学期の表彰式・終業式・校歌の練習を体育館で実施しました。
校歌を全校生徒で練習するのはコロナ禍以来初めてのことで、戸惑いながらも頑張って歌いました。
次回、さらなるパワーを注入して元気に歌えることを願っています。